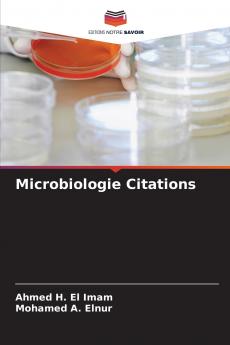
Microbiologie Citations

French
Paperback
₹7674
₹10597
27.58% OFF
(All inclusive*)
Delivery Options
Please enter pincode to check delivery time.
*COD & Shipping Charges may apply on certain items.
Review final details at checkout.
Looking to place a bulk order? SUBMIT DETAILS
About The Book
Description
Author(s)
Microbiologie Les citations résument organisent et simplifient les informations fondamentales couvrant la microbiologie générale et systémique. Cette citation est d'un grand intérêt conçue de manière à rendre l'information plus accessible claire et uniforme. Plusieurs efforts ont également été faits pour améliorer la lisibilité du texte. Tous les étudiants médecins diplômés scientifiques et professionnels de la santé peuvent acquérir des connaissances avec peu d'efforts. Ce livre a été écrit principalement pour mettre à jour réorganiser et recentrer sur les maladies bactériennes virales et parasitologiques. La première partie couvre les concepts de base de la microbiologie et la deuxième partie cite les aspects précis de diverses maladies microbiologiques. Le livre explore comment les citations peuvent mieux présenter les conseils essentiels et la fiche d'information sur la maladie et sa pathogenèse l'épidémiologie le diagnostic le contrôle et le traitement en vue d'un diagnostic précoce d'un traitement rapide du contrôle et de l'éradication future.
Delivery Options
Please enter pincode to check delivery time.
*COD & Shipping Charges may apply on certain items.
Review final details at checkout.
Details
ISBN 13
9786208750862
Publication Date
-17-03-2025
Pages
-132
Weight
-190 grams
Dimensions
-152x229x7.86 mm